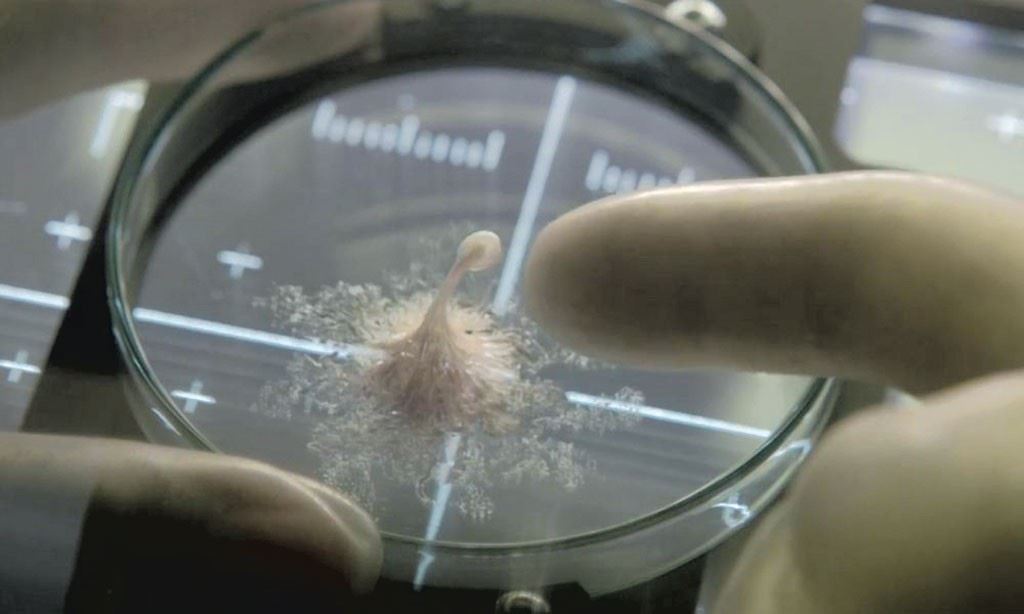
microbes “unknown to science” discovered on international space station

Main image via Sony Pictures , NASA
Advertisement
We’ve seen countless movies about unknown lifeforms or bacteria discovered in space that turn into something far worse, and a similar scenario is actually happening in real life!
Four different strains of bacteria were revealed to have been living on the International Space Station, with three of the strains “were, until now, completely unknown to science.”

One strain of the bacteria was found on an overhead panel of the ISS research stations, another in the Cupola observatory module, and the third and fourth found on the surface of the dining table and an old HEPA filter that returned to Earth in 2011.
But unlike something you've see out of the 2017 feature film Life starring Jake Gyllenhaal, Rebecca Ferguson, and Ryan Reynolds, they are not harmful bacteria and are actually beneficial to the ISS.
"To grow plants in extreme places where resources are minimal, isolation of novel microbes that help to promote plant growth under stressful conditions is essential," a statement by Dr Kasthuri Venkateswaran (Venkat) and Dr Nitin Kumar Singh of NASA's Jet Propulsion Laboratory said.
It was also revealed that the microbes samples will not be sent to earth for tests, but instead will be scanned in space with the scans being sent back to earth.

"Instead of bringing samples back to Earth for analyses, we need an integrated microbial monitoring system that collect, process, and analyze samples in space using molecular technologies," Venkat and Singh added.
"This miniaturized 'omics in space' technology - a biosensor development - will help NASA and other space-faring nations achieve safe and sustainable space exploration for long periods of time."
One of the strains also had promising genes that can help with plant growth and one which promotes cell division in roots and shoots.

Researchers acknowledged that there is still more to find out about microbial diversity and that around 1,000 samples have been collected at the ISS.
So if you’re wondering if this might turn out to be a horror alien movie, the answer is no!
What are your thoughts on it? Let us know!
Info via Scientist Alert